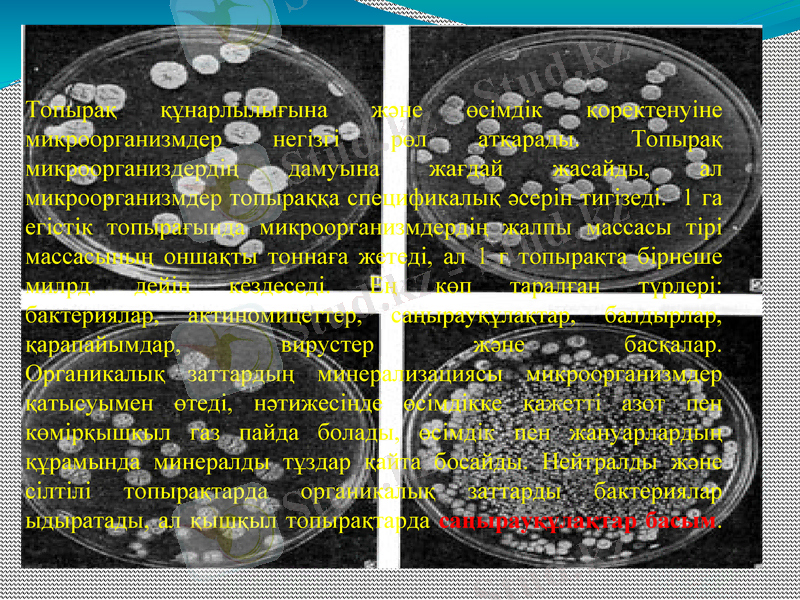
Slide 7

Топырақтағы микроорганизмдер: түрлері және топырақ құнарлылығындағы рөлі



Топырақтағы мекендейтін
микроорганизмдердің түрлері мен ролі.

Жоспар:
І. Топырақтағы микроорганизмдер маңызы
ІІ. Микроорганизмдердін түрлері
А. Бактериялар
Б. Актиномицеттер
В. Саңырауқұлақтар
С. Балдырлар
Д. Қарапайымдылар
Е. Вирустар
ІІІ. Биологиялық сіңіру

Топырақты мекендейтін, онда өсіп-өнетін организмедердің молдығы топыраққа жай ғана әсер етіп қоймай, топырақтағы көптеген қосылыстардың бағытына, олардың қасиеттеріне зор ықпал етті. Мәселен топырақтың әр зонада орналасуына қарай, олардың әрбір граммында мыңдаған, миллиондаған, тіпті миллиардқа шейін микроорганизмедр кездеседі. Олар да өнеді, өседі, өледі. Топыраққа түскен бүкіл органикалық заттарды ірітіпөшірітіп, ыдыратып, оларды әртүрлі газдарға, минералды заттарға бөлетін, органикалық заттардан күрделі топырақ шіріндісін (гумусты) түзетін осы - микроорганизмдер.

Микроорганизмдердің түрлері

Топырақта микроорганизмдер және төменгі сатылы өсімдіктер: негізінен бактериялар, кейбір балдырлар, саңырауқұлақтар мен қыналар көп кездеседі. Бұлардың ішінде топырақта ең көп тарағаны - бактериялар.
Топырақта микроорганизмдердің түрлері мен санының әр түрлі болуы ондағы табиғижағдайлардың, яғни топырақтың түрліше болуына байланысты.
Ғылыми деректерге сүйенсек: құнарлы қара топырақтың бір грамында бактерия саны 5 миллиардқа, құнары аздау күлгін топырақта оның саны 1 миллиардтай екен. Еліміздің көрнекті микробиолог ғалымы Н. А. Красильниковтың есептеуіне қарағанда топырақтың құнарлы қабатында гектарына 5-7 тоннаға дейін тірі бактериялар болады екен (КрасильниковН. А., 1954)

Топырақта негізінен бактериялар, актиномицеттер, ашытқы саңырауқұлақтар, микроскоптық саңырауқұлақтар, балдырлар қарапайым организмдер түрлі насикомдар кездеседі.
Бастапқы немесе шамалы топыраққұралу процесі қатты тау жыныстар (массасы кристалды қалыптасқан) бетінде айқын өтеді. Көптеген ғалымдар (топырақ пен микроб зерттеушілер, геохимиктер; Вернадский, Полынов, Виноградов, Глазовская, Парфенова т. б. ) зерттеулері көрсеткендей шың тасты, физикалық үгілмес бұрын, тірі организмдер жайылып, одан тез бастапқы немесе шамалы ТҚ процесі дами бастайды.
Топырақ құнарлылығына және өсімдік қоректенуіне микроорганизмдер негізгі рөл атқарады. Топырақ микроорганиздердің дамуына жағдай жасайды, ал микроорганизмдер топыраққа спецификалық әсерін тигізеді. 1 га егістік топырағында микроорганизмдердің жалпы массасы тірі массасының оншақты тоннаға жетеді, ал 1 г топырақта бірнеше милрд. дейін кездеседі. Ең көп таралған түрлері: бактериялар, актиномицеттер, саңырауқұлақтар, балдырлар, қарапайымдар, вирустер және басқалар. Органикалық заттардың минерализациясы микроорганизмдер қатысуымен өтеді, нәтижесінде өсімдікке қажетті азот пен көмірқышқыл газ пайда болады, өсімдік пен жануарлардың құрамында минералды тұздар қайта босайды. Нейтралды және сілтілі топырақтарда органикалық заттарды бактериялар ыдыратады, ал қышқыл топырақтарда саңырауқұлақтар басым.

Саңырауқұлақтар мен бактериялар топырақ құрамындағы кейбір зиянды бактериялардың көбейіп кетпеуіне ықпал етеді. Өздерікен арнайы зат бөліп, зиянды бактериялардың өсуін тежейді. Оларды антибиотиктер деп атайды. Ондай антибиотиктерге бактериялардан бөлінетін стрептомицин, тетрациклин және саңырауқұлақтардан алынатын пенициллин жатады. Бұл антибиотиктерді өндірісте жасанды жолмен алу жолға қойылған. Адам баласы бұл дәрілерді күнделікті пайдаланады. Соңғы кезде медицинада жүректі, бүйректі операция жасап ауыстырғанда пайдаланылатын дәріні топырақтағы саңырауқұлақтан бөліп алды. Өсімдіктерді тез өсіретін белсенді зат - гибереллин, зиянды бунақденелілерге қарсы қолданылатын боверинде саңырауқұлақтардан алынады. Саңырауқұлақтардың пайдалы жақтары толық анықтауды қажет етеді.
Жылдан - жылға халық саны өсіп келеді. Адам баласын тағаммен қамтамасыз ету - кезек күттірмейтін мәселе. Сондықтан саңырауқұлақтарды тек дәрі алу үшін ғана емес, тамаққа пайдалану үшін де қолдан өсіреді. Арнайы орындарда қарашірік топыраққа жылқы тезегін қосып, қозықұйрықтың спораларын себеді. Сонда ғана ол ұзақ жылдар түсім береді. Қазір 70 елде қозықұйрық, жазғы түбіртек егу жолға қойылған. Одан жылына 14 млрд доллар қосымша табыс түседі. Қазақстанда да қозықұйрық пен жазғы түбіртекті қолдан өсіру жүзеге асырылуда.

Балдыр (Algae) - төменгі сатыдағы су өсімдіктері. Теңіз, көл, өзендерде, ағынсыз да өседі. Балдырдың клеткалық құрылымы болмайды, бір клеткалы, колониялы, көп клеткалы түрлері бар. Көп клеткалы өкілдерінің денесін таллом деп атайды. Клетка қабығы гемицеллюлозадан және пектинді заттардан тұрады. Клеткасы негізінен бір ядролы. Цитоплазмасында митохондрия, диктиосома, рибосома, хромотофора сияқты органоидтары және вакуолясы (бос қуысы) болады. Балдыр биохимикалық қасиеттеріне және клеткалық құрылымына қарай 12 типке бөлінеді: көкжасыл Балдыр (Cyanophyta), прохлорофитті Балдыр (Prochlorophyta), қызыл Балдыр (Rhodophyta), жалтырауық Балдыр (Chrysophyta), диатомды Балдыр (Dіatomeae), криптофитті Балдыр (Cryptophyta), динофитті Балдыр (Dіnophyta), қоңыр Балдыр (Phaeophyta), сарыжасыл Балдыр (Xanthophyta), эвгленді Балдыр (Euglenophyta), жасыл Балдыр (Chlorophyta), хара Балдыры (Charophyta) . .

Жазда тоған суының кейде жасыл түсті болатынын байқймыз. Ал оның неден болатынын білесіңдер ме? Жылы тоған суында ерекше өсімдіктер балдырлар тез көбейе бастайды. Суды жасыл түске енгізетін солар. Егер сендер «жасыл» суды микроскоппен қарасаңдар, толып кішкентай түйіршіктерді көресіңдер - бұл балдырлардың шоғыры болып табылады. Жер бетінде балдырлардың түрі өте көп. Олардың арасында ұзындығы 40 метрге жететін алыптары бар, олар мұхиттарда өседі. Бар болғаы бір клеткадан тұратын балдырлар да бар. Олар әдетте түйіршіктер шоғырына жиналады және су бетінде осындай сансыз шоғырлар түзіп, оның бетін түрлі түске бояйды. Түсі жөнінен жасыл көк, жасыл, қоңыр және қызыл балдырлар болады. Жасыл көк балдырлар тек суда ғана өспейді. Қазақстан мен Орта Азия шөлдерінде олар топырақ бетінде кездеседі. Бұл жерлерде жаңбыр жауатын көктем мен күзде жасыл көк балдырлар барынша көбейеді, ал құрғақ кезде қабыршаққа айналып топырақ бетін жауып тұрады. Жел бұл қабыршақтарды Жан-жаққа ұшырып әкетеді. Жаңбыр жауса болғаны- жасыл көк балдырлар қайта жанданады.

Жасыл балдырларда топырақ бетіне өсе алады, бірақ олар көбінесе суда тіршілік етеді. Олардың арасында бір клеткалы балдырлар да бар- олар су бетінде қалқып жүреді, ал ірі балдырлар су түбіне бекиді. Қоңыр балдырлардың бәрі ірі өсімдіктер. Олар теңіздер мен мұхиттарда су асты орманын-нағыз джунгли түзеді. Саргасс теңізінде саргасс балдырлары өседі. Теңізде соған орай Саргасс аталған. Бұл балдырлар теңіз жағасында су түбіне бекиді, ал ашық теңізде қалқып жүреді-ығады. Балдыр қалың болған кезде, тіпті олар кемелердің жүзуіне кедергі жасайды. Қызыл балдырларда теңіздер мен мұхиттарда өседі, бірақ олар ыға алмайды, жартастарға, бақалшақтарға немесе басқа балды

Қарапайым жануарларда ішкі қаңқа және омыртқа жотасы болмайды. Сондықтан бұларды жәндіктер тобына жатқызамыз. Біржасушалы жәндіктердің құрылысы өте қарапайым. Олар жалғанаяқтың, талшықтың, кірпікшелердің жәрдемімен қозғалады. Тұщы және тұзды суларда, топырақта өмір сүрелі. Адам мен жануарлар денесінде паразиттік жолмен тіршілік ететін қарапайымдар да бар. Құрылымы қарапайым болса да бұл жәндіктер зат алмастырады, қоректенеді, тыныс алады, қажетсіз заттарды бөледі. Сондай-ақ ол көбейеді, өседі, қозғалады және тіршілігін жолды. Демек бұл - дербес әрекет ететін жасуша - тірі ағза. Көпжасушалы жәндіктердің әрбір жасушасы бірігіп, топтасады. Сөйтіп өз алдына әр түрлі қызмет атқарады.
Ал біржасушалы жәндіктердің бір өзі ғана барлық жүйелердің қызметін толық атқарады. Қарапайымдар санының көп болуы және кең таралуы табиғатта маңызды рөл атқарады. Бұлар бактериялар мен біржасушалы балдырларды және жәндіктерді қорек етеді. Ал өздері көптеген жәндіктер мен жануарларға жем болады. Қарапайым жәндіктердің ауыл шаруашылығында және адам денсаулығын сақтауда маңызы зор. Жер бетінде ағзалық заттардың, тірі ағзалардың пайда болуы мен дамуы проблемасын шешуде біржасушалы жәндіктерге ерекше назар аударылады. Қарапайымдардың шоғырланып тіршілік ететін түрлері де бар. Солардың түрлерін зерттеп білу нәтижесінде көпжасушалы жәндіктердің пайда болу жолдарын айқынырақ түсіндіре аламыз.

Қарапайымдар, яғни біржасушалы жәндіктер типіне жататын ағзалар қозғалу тәсілі мен көбею әрекеттеріне байланысты бірнеше (7) типке бөлінеді. Бізге солардың үшеуі: саркоталшықтылар, кірпікшелілер және споралылар типі көбірек таныс.
Саркоталшықтылар типі екі типтің, атап айтқанда саркодина және талшықтылар типтерінің қосындысы. «Саркодина» грекше «саркос» - плазма, яғни плазмалық жарғақшалы дегенді білдіреді. Саркодиналар жалған аяқ түзіл, дене пішінін үнемі өзгерте алады. Бұл - ағза денесін қаптаған, микроскоп арқылы ғана көрінетін өте жұқа плазмалық жарғақшаға байланысты құбылыс. («Плазма» дегеніміз қоймалжың сұйықтан түзілген жұқа қабықша немесе жасуша ішіндегі цитоплазма. ) Бұл типке жататын жәндіктер теңізде, тұщы сула тіршілік етеді.
Олардың паразиттік жолмен тіршілік ететін де түрлері бар. Кейбіреуі тіпті батпақты жерлер мен топырақта да тіршілік ете алады. Саркодиналардың дене пішіні тұрақты емес. Жалған аяқтарын дененің кез келген жерінен созыл шығарады. Сондықтан оларды «тамыраяқтылар» деп те атайды. Саркодиналарға жататын кейбір ағзалардың денесін әктен түзілген сыртқы қаңқа қаптайды. Олардың дене пішіні өзгермей сақталады. Сәулелі өрмекаяқ, қошқармүйіз көпірме және шұрықденелі бунақай - дене пішіндері тұрақты жәндіктер.

Вирус (лат. virus - яд) - субклеточный инфекционный агент, который может воспроизводиться только внутри живых клеток организма. По природе вирусы являются автономными генетическими элементами, имеющими внеклеточную стадию в цикле развития. Вирусы представляют собой микроскопические частицы, состоящие из молекул нуклеиновых кислот - (ДНК или РНК, некоторые, например, мимивирусы, имеют оба типа молекул), заключённые в белковую оболочку, способные инфицировать живые организмы

Белковая оболочка, в которую упакован геном, называют капсидом. Наличие капсида отличает вирусы от вирусоподобных инфекционных нуклеиновых кислот - вироидов. Вирусы, за редким исключением, содержат только один тип геномной нуклеиновой кислоты. Классифицируют ДНК-содержащие вирусы и РНК-содержащие вирусы, на чем основана классификация вирусов по Балтимору. Ранее к вирусам также ошибочно относили прионы, однако впоследствии оказалось, что эти возбудители представляют собой особые инфекционные белки и не содержат нуклеиновых кислот

Топырақты мекендейтін әрбір организм қоректік элементтерді сіңіруде талғампаздық танытады. Атап айтқанда, өсімдік тамыры мен микроорганизмдер топырақтан тек қана өздеріне қажетті элементтерді сіңіреді.
- Іс жүргізу
- Автоматтандыру, Техника
- Алғашқы әскери дайындық
- Астрономия
- Ауыл шаруашылығы
- Банк ісі
- Бизнесті бағалау
- Биология
- Бухгалтерлік іс
- Валеология
- Ветеринария
- География
- Геология, Геофизика, Геодезия
- Дін
- Ет, сүт, шарап өнімдері
- Жалпы тарих
- Жер кадастрі, Жылжымайтын мүлік
- Журналистика
- Информатика
- Кеден ісі
- Маркетинг
- Математика, Геометрия
- Медицина
- Мемлекеттік басқару
- Менеджмент
- Мұнай, Газ
- Мұрағат ісі
- Мәдениеттану
- ОБЖ (Основы безопасности жизнедеятельности)
- Педагогика
- Полиграфия
- Психология
- Салық
- Саясаттану
- Сақтандыру
- Сертификаттау, стандарттау
- Социология, Демография
- Спорт
- Статистика
- Тілтану, Филология
- Тарихи тұлғалар
- Тау-кен ісі
- Транспорт
- Туризм
- Физика
- Философия
- Халықаралық қатынастар
- Химия
- Экология, Қоршаған ортаны қорғау
- Экономика
- Экономикалық география
- Электротехника
- Қазақстан тарихы
- Қаржы
- Құрылыс
- Құқық, Криминалистика
- Әдебиет
- Өнер, музыка
- Өнеркәсіп, Өндіріс
Қазақ тілінде жазылған рефераттар, курстық жұмыстар, дипломдық жұмыстар бойынша біздің қор #1 болып табылады.



Ақпарат
Қосымша
Email: info@stud.kz